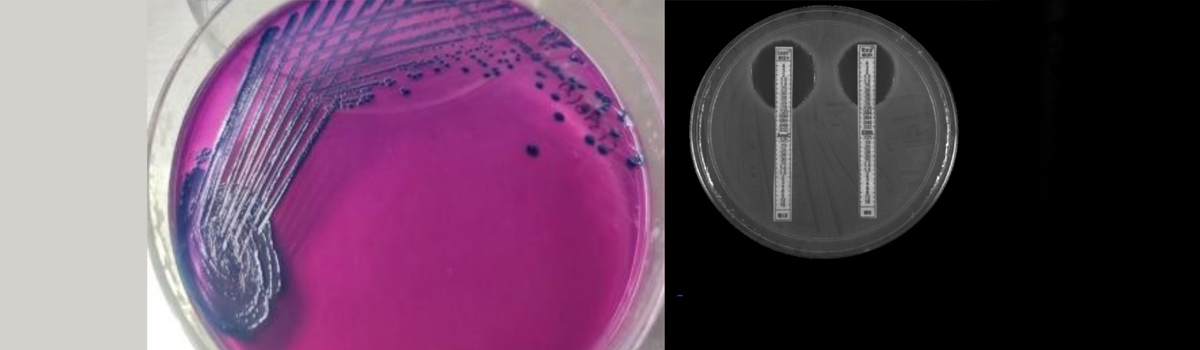
Fisheries Resources, Harvest & Post-Harvest Management Division

Fisheries Resources, Harvest & Post-Harvest Management Division

The Division of Fisheries Resources Harvest and Post-Harvest Management has been instrumentalin the stewardship and sustainable exploitation of fisheries and associated biological resources within the nation, propelled by advancements in human resource development. Present research endeavors are directed towards Biodiversity and Sustainable Fisheries Management, encompassing projects such as the cataloging of ornamental freshwater fish resources in Maharashtra's rivers, analysis of mangrove ecosystems and their crustacean biodiversity, exploration of Artemia diversity across the northern coastal regions of Maharashtra, and the taxonomical and biochemical assessment for the sustainable use of brown algal species. Further, the division is engaged in the identification and characterization of nursery areas for key small pelagic fish species along the Maharashtra coast, studying the biology of Osteobrama vigorsii in the Bhima River basin, and employing remote sensing and GIS for the trophic state assessment of select reservoirs and spatial fish abundance forecasting. Innovations in dolnet fishing methods aim to enhance sustainable fisheries management by comparing mesh size effects on catch composition.
Climate resilience is addressed through research on the impacts of biotic and abiotic factors on bivalve responses to ocean acidification and enhancing lipid content in Ulva species for biodiesel production. Efforts in sustainable aquatic resource utilization also extend to seafood quality enhancement and value addition, exemplified by technology demonstrations for high-quality Masmin production for both domestic and international markets, development of fish sausage from major Indian carps, microbial transformation of fish scale waste into bioactive compounds, assessing Arcobacter sp. prevalence in seafood and developing rapid detection techniques, investigating microplastic pollution in fisheries products, and analyzing the biochemical composition and bioactive properties of selected brown seaweedS.
List of Services/ Training provided
- Fish species identification
- DNA barcoding for authentication
- Water quality analysis
- Identification of eggs and larvae of fish species
- Fish processing and value added fishery products
- Antimicrobial Resistance in Food Fish
- Microbiological & molecular biological techniques in seafood quality analysis
- Fatty acid analysis of fish and feed samples
- Fish aquatic biodiversity museum
- HRD programme for students and researchers
List of Training
- Short-term training on Basics of fish biology and its applications
- Short-term training on Molecular Taxonomy & DNA Barcoding
- Drone based technology on fisheries resource management.
- Winter school on “Antimicrobial Resistance in Food Fish: Challenges & Mitigation”
- STP on “Microbiological quality testing of seafood- Tools and techniques”
- Value added fish and shellfish products
- Dry fish handling and value added fish products
- Back to previous page
- |
-
Page last updated date:01-07-2025 03:46 PM
 भारत सरकार | Government of India
भारत सरकार | Government of India

















